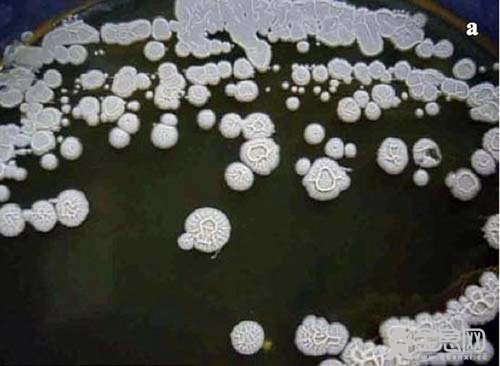

俄罗斯科学家宣称,他们发现一种350万年“永生”细菌,并在其适应性研究上取得突破性进展,从而有望实现人类益寿延年的梦想。这种名为“杆菌F”的细菌发现于西伯利亚永冻土中,至今已存活350万年。
科学家表示,已经解开这种名为“杆菌F”的细菌细胞的DNA秘密,并努力研究分析其基因特征,以探究其在西伯利亚永冻土中是如何生存下来的。图中显示的是试管中的杆菌F。
这种杆菌最初于6年前被发现,发现地为萨哈共和国猛犸象山古老的永冻土层。
据国外媒体报道,长久以来,人类一直梦想着找到一种“仙丹”,吃了可以永葆青春,长生不老。近日,俄罗斯秋明科学中心的研究人员宣称,他们发现了一种350万年前的“永生”细菌,并在其适应性研究上取得突破性进展,从而有望实现人类延年益寿的梦想。科学家表示,已经解开这种名为“杆菌F”细胞的DNA秘密,并努力研究分析基因特征,以探究其在西伯利亚永冻土中的生存机制。实验发现,杆菌F能刺激人血细胞、老鼠、果蝇和农作物的生长,并加强其免疫系统。 秋明科学中心项目负责人谢尔盖-佩特洛夫教授指出:“在所有的实验中,杆菌F均起到了刺激生长和加强免疫系统的作用。在对人体白细胞和红细胞的实验中,我们发现杆菌F的影响非常积极乐观。”2009年,在萨哈共和国猛犸象山古老的永冻土层中,莫斯科大学冻土学系主任安那托里-布鲁契科夫博士发现了这种杆菌。萨哈共和国又称雅库特共和国,是西伯利亚最大的一个行政区。在保存在冻土层现已灭绝的猛犸象大脑中,西伯利亚科学家弗拉迪米尔-列宾也发现了类似的杆菌。

实验发现,杆菌F能刺激老鼠的生长,并加强其免疫系统

实验发现,杆菌F能刺激农作物的生长,并加强其免疫系统。研究人员称,还需要更深入探究其工作机制

2009年,科学家在西伯利亚冻土层中发现这种杆菌,它似乎有望成为一种长生不老药。图中是俄罗斯西北部的一处景象
布鲁契科夫博示称:“我们在老鼠和果蝇身上进行了大量实验,结果发现这种杆菌对它们的寿命和生殖力均有明显积极的作用。但是,我们还不知道这种杆菌的工作机制。”流行病学家维克多-谢尼亚夫斯基解释说:“这种杆菌在整个生命阶段,都会释放出生物活性物质,可以激活实验动物的免疫系统。这的确是一个‘科学奇闻’。实验中,奶奶级老鼠不但开始跳舞,还会生育繁殖。未来,这种杆菌将有望提高人体免疫力,并令科学家发明‘长生不老药’成为可能。”《西伯利亚时报》报道,据称在永冻土中发现的另一种细菌,能够毁掉石油分子,将它们变为水,从而令科学家有望在未来创造出一种清除溢油的新型系统。
布鲁契科夫博示补充说:“我们还发现一种古菌菌株,能够清除纤维分子。我们希望通过研究,了解基因组的保护机制,以及基因的功能原理。问题的关键在于,是什么提供了这种杆菌的活力,然而这种研究的复杂程度毫不亚于研究癌症的病因以及医治方法。
维克多-谢尼亚夫斯基博士指出,未来,这种杆菌将有望提高人体免疫力,并令科学家发明‘长生不老药’成为可能。据称,在永冻土中发现的另一种细菌,能够毁掉石油分子,将它们变为水,从而令科学家有望在未来创造出一种清除溢油的新型系统。
维克多-谢尼亚夫斯基博士解释说:“这种杆菌在整个生命阶段,都会释放出生物活性物质,可以激活实验动物的免疫系统。”
据我们估计,发现这种杆菌的永冻土已有350万年历史,它将杆菌F与外界隔离开,因此我们猜测杆菌F的存活时间长达350万年。当然,我们还需要进一步验证这个猜测。可以说,这里的冻土层中保存着不死的细菌,它们不会死,准确地说就是,它们会自我保护。然而,人类的细胞无法保护其免于损伤。通过研究它们免于衰老和损伤的保护机制,我们将有望战胜衰老。
衰老和死亡是人类世界最大的谜,我们将致力于解开这个谜。如今,科学家在古老的极端环境中,发现了这种杆菌,也就是说我们拥有了一把解开谜底的钥匙。”佩特洛夫教授指出,实验显示这种杆菌能够刺激农作物生长,提高生产力,并且抗霜冻能力也明显增强。
(责任编辑:王翔)
声明:文章版权归原作者所有,本文摘编仅作学习交流,非商业用途,所有文章都会注明来源,如有异议,请联系我们快速处理或删除,谢谢支持。
(原文章信息:标题:科学家发现350万年杆菌:有望解开长生,作者:权静姝,来源:未知,来源地址:)